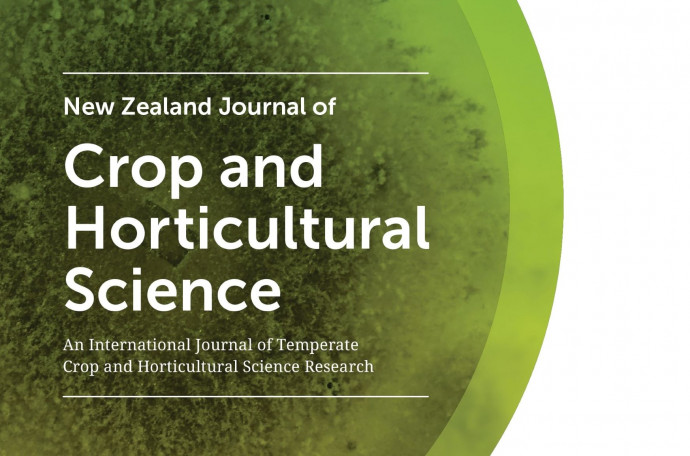

News
Published 29 October 2020Call for Associate Editors announcement
The 'New Zealand Journal of Crop and Horticultural Science' is currently seeking energetic, qualified and committed researchers at any career stage to join the editorial team as Associate Editors.
The New Zealand Journal of Crop and Horticultural Science is an international, peer-reviewed journal. It publishes scientific articles on all aspects of production, protection, handling, and processing of crop and horticultural products of relevance to the Australasian region. It is an official journal of Royal Society Te Apārangi published quarterly in partnership with Taylor & Francis.
To help us to build on the success of this journal and respond to the increasing number of submissions from across the globe, we are looking for multiple dynamic researchers to join New Zealand Journal of Crop and Horticultural Science’s editorial team.
Candidates should be active, publishing researchers and well-connected, both within New Zealand and beyond, although prior editorial experience is not required. We seek for our journal editors to represent the diversity of New Zealand researchers, so we will consider candidates at any level of career and particularly welcome female applicants and those from an ethnic minority.
Expertise required
Candidates should bring to the journal expertise in one of the following topic areas:
Biotechnology, entomology, plant nutrition, plant physiology, breeding, pathology, indoor and urban horticulture, postharvest physiology, viticulture, biosecurity, crop science, new crop and horticultural products.
Agronomy and soil science, cropping systems, precision agriculture, agroclimatology and agronomic modelling, production agriculture, climate change and crop production.
Responsibilites
The responsibilities for Associate Editor include:
- Manage the peer-review process for approximately 5 manuscripts per year in a fair, timely, and thorough way;
- Handle and assess papers outside your immediate research field when needed;
- Identify themes for special issues which you might also help to organize and/or guest-edit;
- Attract new authors and submissions;
- Submit some of your own work for consideration;
- Advise on journal policy and scope;
- Act as advisor in the case of complex publishing ethics discussions when needed;
- Promote the journal to peers and colleagues and represent the journal at conferences.
To be considered for the position, you will have:
- An excellent track record of peer-reviewed publications (considered in relation to career stage);
- A good network of contacts within relevant fields in New Zealand and overseas;
- Research experience in crop and horticultural science with a doctorate degree;
- Interest in digital communication and publishing trends;
- Excellent communication and interpersonal skills;
- The ability to organize, prioritize, and focus;
- The ability to read and assess the novelty, context and implications of research submitted to the journal from different areas of this discipline;
- A willingness to meet researchers on various occasions, learn more about them and their research, and help them to learn more about us;
- The ability to work cooperatively with fellow editors of the journal.
Term and Remuneration
The first term of appointment will be 2 years, renewable thereafter by negotiation.
Associate Editors receive an honorarium of NZ$150 per manuscript handled, payable to either the editor or their institution, by arrangement.
How to apply
Applicants should submit a CV and a one-page cover letter describing why you are interested in the job and how your skills, knowledge, and background would contribute to the journal.
Please send your application by email to Publish@royalsociety.org.nz.
The editorial team is committed to advancing gender equality and promoting diversity.
Closing date
Applications will be considered on a rolling basis until 4th December; therefore early applications are encouraged.
